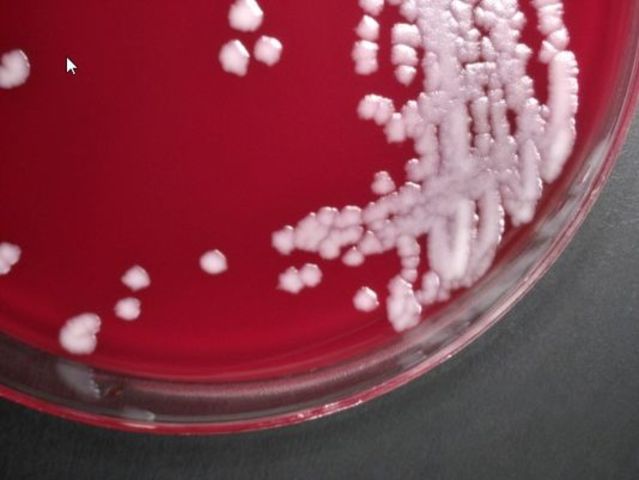
Anthrax Outbreak

-
Blankets infected with smallpox are used to infect indians
-
leading scientific in Bio-chemical Weapons
-
The Geneva protocol made it illegal to employ chemical or biological weapons but did not ban the production or stockpiling of such arms.
-
10,000 prisoners were killed in the experimentation of Korean biological weapons. Prisoners were experimented on with bacterial dysentery and many other types of disease.
-
The Italian army used mustard gas during the invasion of Ethiopia.
-
The Nazis infected the prisoners with Hepatitis A. They studied the results in order to find vaccinations for these types of diseases.Nazis didn't want to weaponize it.
-
Unit 731 weaponized rats infected with the plague. They harvested the fleas off of them to make flea filled bombs. These bombs infected people from China.
-
This program was a large-scale biological weapon production. They produced over 5,000 anthrax bombs.
-
Great Britain dropped an anthrax bomb on Gruinard Island off the coast of Scottland to test the effectiveness of their new weapon.
-
This is a program that started in Arkanas. It is a bacterial production facility. This program helped in the production of most of the U.S. biological weapons.
-
This bomb was approved by the U.S. Department of Agriculture. The anitcrop bomb was put in the protection of both the Department of Agriculture and the Air Force
-
At the end of the Krorean war the weaponization of microorganisms offically started worldwide. Countries didnt just weaponize microorganisms, they also started programs to study on how to protect their troops from biological weapons.
-
President Nixon orders the stop of porduction of all toxic weapons. He signed an executive order to stop all research for offensive biological weapons.
-
he U.S. and other countries sign the Biological Weapons Convention. This says that no country can stockpile biological weapons for military purposes. Russia and Iraq have violated this document.
-
A Bulgarian exile named Georgi Markov was stabbed and infected with ricin. The ricin took days to kill him. This is one of the first incidences to show bio-terrorism.
-
A biological weapons plant mistakenly released anthrax spores. The anthrax killed an unknown amount of people. A laboratory confirmed that there were four different strains of the anthrax spore.
-
This group released a nerve agent in Tokyo subway stations. They killed 12 people and injured several others. This cult has attempted many other times to do this again.
-
The US says it has evidence that sarin was used in an attack in a Damascus suburb. The US estimates that more than 1,400 people were killed in the August 21 attack.
Looking for a timeline maker?
Create timelines for projects, roadmaps, history, lessons, legal cases, and stories with Timetoast. Timetoast is a timeline maker for work, school, research, and stories.